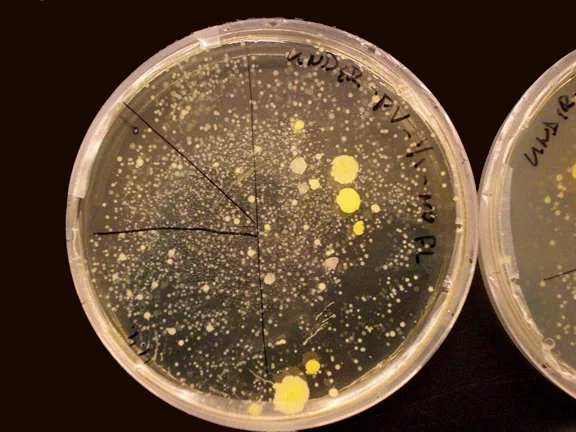

Labor
In Paul Vanouse's in-progress design, two stainless steel cylinders embedded in a complex network of hoses stand on either side of a steel podium. Upon the podium is a glass apparatus, resembling a giant lightbulb. The bulb contains a hung white t-shirt. At the top of the bulb is a nipple with two hoses sprouting out. The cylinders ferment bacteria that is associated with human body odor. They are fed and kept alive through the array of tubes and nozzles that feed into the cylinders. The live bacteria are then soaked into the white T-shirt in the center. The two nozzles at the top allow for scent to be released, but are capped so that microbes cannot escape. This piece is currently being built. All descriptions are based off of concept art.
The focus of this is the emotional dichotomy between the exploitative nature of capitalist labor and the cultural sentimentality that we have towards it, especially as hard labor has become the territory of machines. As manual labor becomes more and more obsolete in many fields, a sense of nostalgia for the idea of the “working man” grows larger. Though tempting in its overt sentimentality, this idea forgets the inherently exploitative nature of labor. The bacteria is brought into life and toils to grow for the sole reason that the it’s scent brings about interesting memories for the viewer. It's very life has been commodified. It frames the senseless imprisonment and brutality that is inherent in the neo-colonial labor market.
“In his new and ongoing project, Labor, the artist shifts from DNA to bacteria as his medium but he keeps addressing strongly socio-politics influenced topics, as labor exploitation.”
Within our capitalistic mindset it is easy to see each facet of the market as modular and self-rationalizing. The worker works to survive, the consumer buys to improve their life, and the entrepreneur is a needed middleman between the two. This piece allows the view to see the process from afar and witness the rungs of oppression that it creates. The bacteria are cultivated and an unnatural and inherently exploitative chamber for such a petty need. The artist himself is not an arbiter delivering goods between the producer and the consumer, but rather a fabricator who exploits a sense need to draw both parties into a pointless cycle of creation and absorption. The viewer himself is an enabler, allowing and even praising these machinations.
The cost of the contraption adds another layer of absurdity to the piece. The drums, the shirt, and the bacteria all require significant resources to produce. All of this money, energy, and time only to create something that occurs naturally, and often involuntarily. Labor critiques capitalism's tendency to commodify and market even undesirable parts of life on the basis of sentimentality.
The spirit of Labor is similar to that of Jasmine Temple's agar artwork, Sunset at the End. For her piece, Temple selected numerous colorful species of bacteria and cultivated them on a gel plate to render a beautiful sunset. Each different color is produced by a different breed of yeast. According to temple: "I was struck by the beauty of the sunset and I thought of how beautiful it would be in the pink, blue and purple yeast strains." Both Sunset and the End Labor use scientific skills that exist traditionally only within hard biology to try and elicit a sentimental response from the viewer. They both experiment with the rift between art and science as well as humanity's potential to find emotional meaning from even bacteria.
Sunset at the End
Labor is also similar to Vanouse's other piece, Ocular Revision. For this Vanouse magnetized a dish of agar so that the electrical output of human DNA would cause it to polarize and appear in a "loading-bar" format. Ocular Revision takes something as intangible as DNA and allows it to be easily viewed. Both this and Labor attempt to take the invisible building blocks of emotion, bacteria and DNA, and make them not only perceptible, but sentimental. Vanouse draws on human perception to create an emotional reaction to familiarity. In Labor this appears as smelling sweat, and in Ocular Revision it is seeing the familiar loading bar.
Ocular Revision
http://www.paulvanouse.com/labor.html
http://www.clotmag.com/paul-vanouse
https://www.asm.org/index.php/public-outreach/agar-art
http://www.paulvanouse.com/or.html
http://www.digiart21.org/art/ocular-revision-1